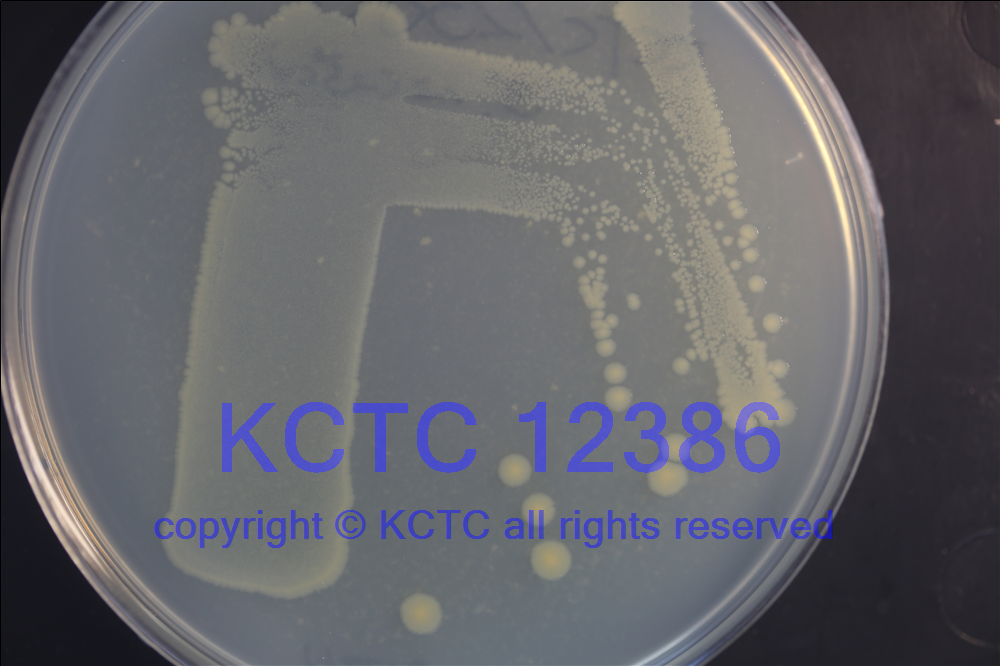

拉丁學名 Aliivibrio fischeri
曾用名
中文譯名 費氏另類弧菌
原始編號 DSM 507
菌株來源 ←DSMZ
保藏人 周宇光
直接來源國家 德國
保藏時間 3/24/2005
其他保藏編號 =ATCC 7744 =NCMB 1281 KCTC 12386
生物危害 四類
模式菌株 模式菌株
菌株用途 模式菌株
培養(yǎng)溫度 20-25℃
培養(yǎng)基 0223
其他培養(yǎng)條件 液體培養(yǎng)
分離源
采集地點
采集國家
Genbank(保藏人)
參考文獻
價格 B